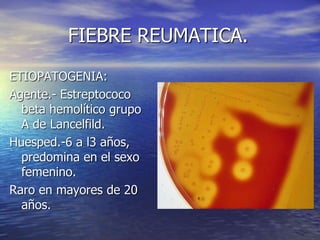
FIEBRE REUMATICA.
ETIOPATOGENIA:
Agente.- Estreptococo
beta hemolítico grupo
A de Lancelfild.
Huesped.-6 a l3 años,
predomina en el sexo
femenino.
Raro en mayores de 20
años.

La fiebre reumática es un trastorno inflamatorio causado por una respuesta inmune a una infección estreptocócica que afecta principalmente a niños y jóvenes. Puede causar inflamación del corazón, las articulaciones, el pericardio y las válvulas cardíacas. El tratamiento incluye reposo, medicamentos antiinflamatorios y antibióticos para prevenir recaídas.